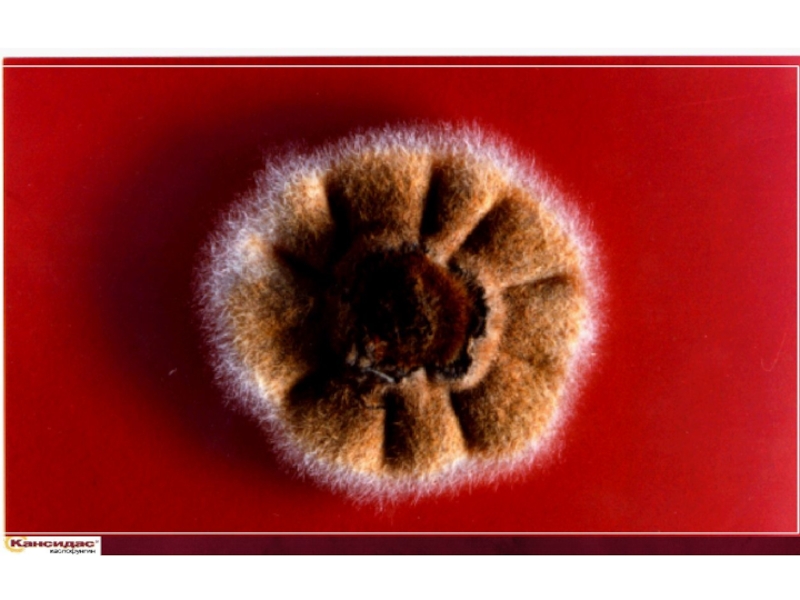

Разделы презентаций
- Разное
- Английский язык
- Астрономия
- Алгебра
- Биология
- География
- Геометрия
- Детские презентации
- Информатика
- История
- Литература
- Математика
- Медицина
- Менеджмент
- Музыка
- МХК
- Немецкий язык
- ОБЖ
- Обществознание
- Окружающий мир
- Педагогика
- Русский язык
- Технология
- Физика
- Философия
- Химия
- Шаблоны, картинки для презентаций
- Экология
- Экономика
- Юриспруденция
ИКС Антибиотико резистентность 30 слайдов
Содержание
- 1. ИКС Антибиотико резистентность 30 слайдов
- 2. Слайд 2
- 3. Слайд 3
- 4. Слайд 4
- 5. Слайд 5
- 6. Слайд 6
- 7. Слайд 7
- 8. Слайд 8
- 9. Слайд 9
- 10. Слайд 10
- 11. Слайд 11
- 12. Новые клинические данные
- 13. Содержание1. КАСПОФУНГИН – первый эхинокандин 2. Эффективность при
- 14. 1. Каспофунгин – первый эхинокандин
- 15. Слайд 15
- 16. -(1,3)-глюканЭргостеролТрадиционная мишень – клеточная мембрана 1Мишень КАСПОФУНГИНа
- 17. 2. Эффективность при инвазивном кандидозе
- 18. Основные заболевания / факторы риска 1**У некоторых
- 19. Общая переносимость 11. Mora-Duarte J, Betts R,
- 20. Клинические нежелательные явления, связанные с препаратом 11.
- 21. Частота отмены лечения 11. Mora-Duarte J, Betts
- 22. 3. Эффективность при инвазивном аспергиллезе
- 23. 1. Bowman JC, Scott Hicks P, Kurtz
- 24. *У пациентов после трансплантации.1. Edmond MB, Wallace
- 25. Полный ответ = полное исчезновение всех
- 26. 4. Дозирование и лекарственное взаимодействие
- 27. Спектр активности (in vitro)Характеристики препарата КАСПОФУНГИН Candida·
- 28. Дозирование и введение Без расчетов "мг /
- 29. ВЫВОДЫ Уникальный механизм действия Мишень воздействия
- 30. Перед назначением препарата, пожалуйста, ознакомьтесь с полным Проспектом для врачей
- 31. Скачать презентанцию
Слайды и текст этой презентации
Слайд 13Содержание
1. КАСПОФУНГИН – первый эхинокандин
2. Эффективность при инвазивном кандидозе
3. Эффективность при инвазивном
аспергиллезе
Слайд 16-(1,3)-глюкан
Эргостерол
Традиционная мишень – клеточная мембрана 1
Мишень КАСПОФУНГИНа – клеточная стенка
Мишени
воздействия антимикотических препаратов
Уникальный механизм действия
Клеточная
стенка
гриба
Фосфолипидный
бислой
клеточной мембраны
-(1,3)-глюкансинтаза
1. Groll
AH, Piscitelli SC, Walsh TJ. Clinical pharmacology of antifungal agents: A comprehensive review of agents in clinical use, current investigational compounds, and putative targets for antifungal drug development. Adv Pharmacol 1998;30:343-500.Слайд 18Основные заболевания / факторы риска 1*
*У некоторых больных было более
одногофактора риска
1. Mora-Duarte J, Betts R, Rotstein C et al.
Comparison of caspofungin and amphotericin B for invasive candidiasis. N Engl J Med 2002;347:2020-2029.Слайд 19Общая переносимость 1
1. Mora-Duarte J, Betts R, Rotstein C et
al. Comparison of caspofungin and amphotericin B for invasive candidiasis.
N Engl J Med 2002;347:2020-2029.48/114
94/125
3/114
29/125
23/114
61/125
13/114
33/125
8/95
26/105
*
*
*
*
*
* p<0.05
Пропорция пациентов (%)
НЯ – нежелательные явления
Слайд 20Клинические нежелательные явления,
связанные с препаратом 1
1. Mora-Duarte J, Betts
R, Rotstein C et al. Comparison of caspofungin and amphotericin
B for invasive candidiasis. N Engl J Med 2002;347:2020-2029.*
*
* p<0.05
% пациентов с НЯ
Слайд 21Частота отмены лечения 1
1. Mora-Duarte J, Betts R, Rotstein C
et al. Comparison of caspofungin and amphotericin B for invasive
candidiasis. N Engl J Med 2002;347:2020-2029.3%
23%
КАСПОФУНГИН
Амфотерицин B
Слайд 231. Bowman JC, Scott Hicks P, Kurtz M et al.
The antifungal echinocandin caspofungin acetate kills growing cells of Aspergillus
fumigatus in vitro. Antimicrob Agents Chemother 2002;46(9):3001–3012.Эффект воздействия КАСПОФУНГИНА на
Aspergillus fumigatus
Слайд 24*У пациентов после трансплантации.
1. Edmond MB, Wallace S, McClish D
et al. Nosocomial bloodstream infections in United States hospitals: A
three year analysis. Clin Infect Dis 1999;29:239–244;2. Denning DW, Stevens DA. Antifungal and surgical treatment of invasive aspergillosis: A review of 2,121 published cases. Rev Infect Dis. 1990;12(6) 1147-1201.
Aspergillus до 90%2*
Candida 40%1
Летальность
Летальность при инфекциях, вызванных Candida и Aspergillus
Есть необходимость в эффективном и хорошо переносимом лечении
Слайд 25 Полный ответ = полное исчезновение всех присущих признаков и
симптомов (в т.ч. - рентгенологических)
Частичный ответ = клинически
значимое улучшение по всем присущим признакам, симптомам (в т.ч. рентгенологическим) Анализ эффективности – благоприятный ответ
Документированный аспергиллез1
1. Данные компании MSD
Представлены последние данные, полученные в ходе исследования КАСПОФУНГИН для терапии "спасения" при инвахивном аспергиллезе (n=90).
Слайд 27Спектр активности (in vitro)
Характеристики препарата КАСПОФУНГИН
Candida
· C. albicans
· C.
dubliniensis
· C. glabrata
· C. guilliermondii
· C. lipolytica
· C. kefyr
· C.
krusei · C. lusitaniae
· C. parapsilosis
· C. tropicalis
· C. rugosa
·C. pseudotropicalis
Aspergillus
· A. flavus
· A. fumigatus
· A. nidulans
· A. niger
· A. terreus
Слайд 28Дозирование и введение
Без расчетов "мг / кг"
Без
премедикации
Время инфузии ≥ 1 час
Не использовать растворители,
содержащие глюкозу*Коррекция дозы
Не нужна при почечной недостаточности
Не нужна, в зависимости от расы или возраста
Не нужна при легкой печеночной недостаточности
Для пациентов с массой тела свыше 80 кг поддерживающая доза
увеличивается до 70 мг
Для пациентов с умеренной печеночной недостаточностью
поддерживающая доза уменьшается до 35 мг
Коррекция дозы может потребоваться при одновременном назначении
с некоторыми индукторами метаболических ферментов
Удобное дозирование 1 раз в сутки
Нагрузочная
доза
70 мг
Поддерживающая
доза*
50 мг
Характеристики препарата КАСПОФУНГИН
Слайд 29ВЫВОДЫ
Уникальный механизм действия
Мишень воздействия - клеточная стенка
грибов
Широкий спектр активности в отношении
видов рода
Aspergillus и CandidaОтличный профиль переносимости
Удобное дозирование и введение один раз в
сутки
Характеристики препарата КАСПОФУНГИН